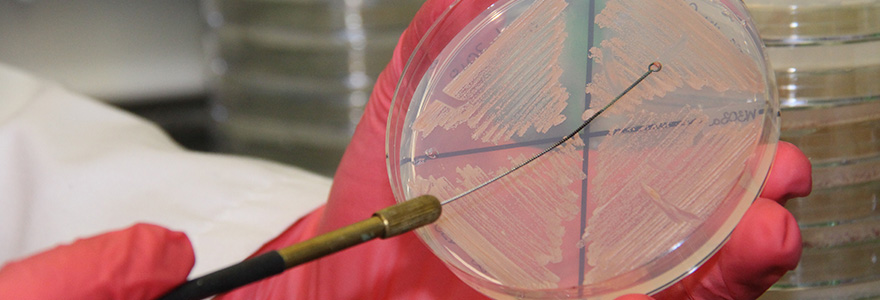

Research
Our research aims to decipher the genetic, cellular, and molecular basis of protein misfolding, the dysfunction of cellular protein quality control, and aging, in neurodegenerative diseases. Protein misfolding in neurodegenerative disease refers to the manifestation of aberrant, often aggregated protein species found in affected neurons. Protein quality control defines all cellular systems that regulate the proper synthesis, maintenance, and degradation of proteins. Protein misfolding and dysfunctional cellular protein quality control systems are strongly associated with most neurodegenerative diseases, including Parkinson’s disease, Huntington’s disease, and ALS. Yet the biological mechanism underpinning these diseases remain mostly unclear. To tackle this problem we apply an innovative experimental approach harnessing the power of model systems, such as yeast, mammalian cells, and rodents, with pathological studies using human specimen in close collaborations with other research teams.
The nexus of aging and protein misfolding in neurodegenerative diseases
- Aged-induced protein misfolding is the basis for several devastating neurodegenerative diseases. Yet it remains mostly unclear how aging contributes to these disorders on a cellular, genetic, and biochemical level. We study this problems by using the genetically and biochemically tractable model organism yeast. Specifically, we will explore chronologically aged yeast cells expressing misfolded polyglutamine-expansion (polyQ) proteins. PolyQ expansion proteins cause nine different age-dependent neurodegenerative diseases, including Huntington’s disease. The yeast polyQ model established by our team recapitulates major hallmarks of polyQ biology, including polyQ aggregation and age-dependent polyQ toxicity, and therefore presents a unique and powerful platform to study age-dependent protein misfolding using the vast experimental repertoire only available for work in yeast.
Parkin malfunction in Parkinson’s disease
- Mutations in the gene encoding the protein parkin cause familial forms of Parkinsonism but parkin malfunction may also contribute to non-familial Parkinson’s disease. Our research asks if oxidative damage, misfolding, and degradation of parkin contribute to the pathogenesis of Parkinson’s disease. Our collaborative research seeks to explore parkin malfunction under cellular stress conditions in Parkinson’s disease, and its potential as a therapeutic target.
Protein misfolding and protein quality control in ALS
- Protein misfolding and protein aggregation are major pathological hallmarks in degenerating neurons of ALS. Recent pathological and genetic findings indicate that the protein RGNEF (Rho guanidine nucleotide exchange factor) may play an important role in ALS. We study how RGNEF and other ALS proteins, such as TDP-43 and FUS, misfold and thereby alter cellular protein quality control and thus contribute to neurodegeneration.
Nrf2 regulation in health and disease
- Nuclear factor erythroid 2-related factor 2 (Nrf2) is the master transcriptional regulator of the cellular defense against oxidative stress by regulating the expression of detoxification enzymes for the removal of harmful substances. Nrf2 acitivity is tightly controlled by its interactions with proteins including Keap1, p21, CBP, and β-TrCP. We seek to decipher how the cellular and molecular basis of these Nrf2 interactions and how their role in cancers and neurodegenerative diseases.








